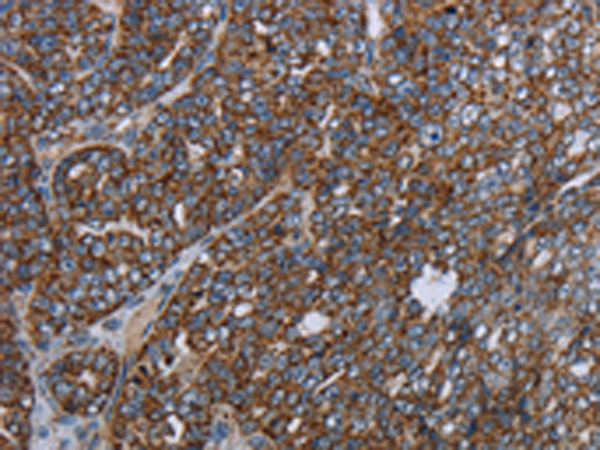
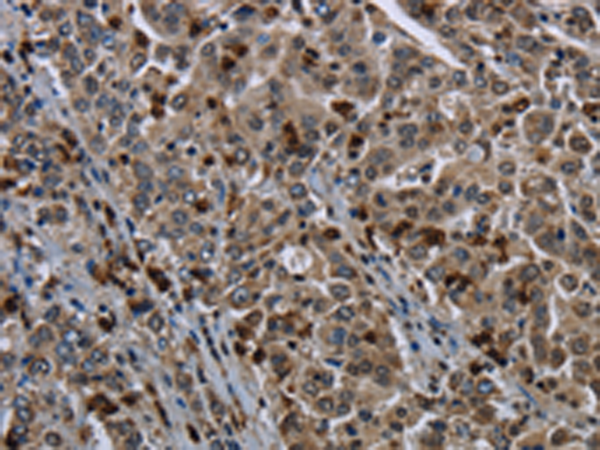

-
分类: 科研抗体货号: P08373别名: GPAT; PRAT; ATASE应用: WB,IHC反应种属: Human, Mouse, Rat
-
分类: 科研抗体货号: P08365别名: GGT; GTG; CD224; GGT 1; D22S672; D22S732应用: WB反应种属: Human, Rat
-
分类: 科研抗体货号: P08385别名: B16.6; CDA016; CGI-39; GRIM19; GRIM-19应用: WB,IHC反应种属: Human, Mouse
-
分类: 科研抗体货号: P08363别名: GDIA1; NPHS8; RHOGDI; RHOGDI-1; HEL-S-47e应用: WB,IHC反应种属: Human, Mouse, Rat
-
分类: 科研抗体货号: P08405别名: CPD; ACPD; VESL-2; HOMER-2应用: IHC反应种属: Human, Mouse, Rat
-
分类: 科研抗体货号: P08383别名: BSS; GP1B; VWDP; CD42B; GPIbA; BDPLT1; BDPLT3; DBPLT3; CD42b-alpha应用: IHC反应种属: Human
-
分类: 科研抗体货号: P08362别名: GCMA; hGCMa应用: WB反应种属: Human, Mouse
-
分类: 科研抗体货号: P08404别名: HOMER; SYN47; Ves-1; HOMER1A; HOMER1B; HOMER1C应用: WB,IHC反应种属: Human, Mouse, Rat
-
分类: 科研抗体货号: P08382别名:应用: WB,IHC反应种属: Human, Mouse
-
分类: 科研抗体货号: P08402别名: LDLCQ3应用: WB,IHC反应种属: Human, Mouse, Rat

鄂公网安备42018502007531号
鄂公网安备42018502007531号

